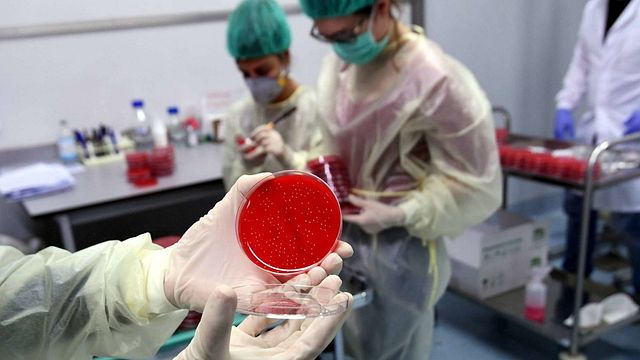

Nelle ultime 24 ore in Italia sono stati registrati 1.452 nuovi casi di positività al Covid-19. Un dato raccolto a fronte di un deciso aumento dei tamponi: 100.607 rispetto agli 80mila di martedì. In leggero aumento i ricoveri in terapia intensiva (+6). I morti a causa del coronavirus nelle ultime 24 ore sono 12.
Attualmente positivi oltre 40mila, mai così tanti da giugno Gli attualmente positivi hanno superato i 40mila, un numero mai così alto dall'inizio di giugno (il 2, per la prima volta dopo mesi, i malati scesero a 39.893). Gli attualmente positivi al Covid-19 sono infatti ora 40.532, di questi, 38.040 si trovano in isolamento domiciliare, 2.285 sono ricoverati con sintomi e 207 sono in terapia intensiva. Il numero complessivo dei contagiati sale dunque a 291.442, mentre quello dei dimessi e guariti è di 215.265, 620 più di ieri. Nessuna regione ha fatto registrare zero casi.